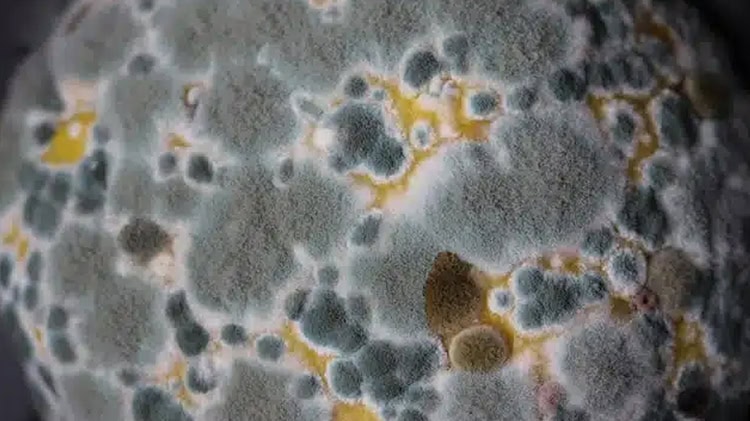

La detección de dos pacientes con una enfermedad pulmonar provocada por un hongo, obligó a las autoridades chilenas a cerrar cinco alas de un hospital público de Chile.
De acuerdo con la información, se trata de una infección micótica ocasionada por el hongo Aspergillius, la cual fue detectada en el Hospital El Pino, ubicado en el municipio de San Bernardo, al sur de Santiago de Chile.
Las alarmas se prendieron luego de que el domingo 4 de mayo de que se diagnosticaran dos pacientes con aspergilosis pulmonar, un padecimiento causado por el referido hongo.
Autoridades sanitarias informaron que esta infección micótica es altamente contagiosa, además de que afecta, principalmente, las vías respiratorias.
A raíz de ello, se ordenó el cierre inmediato de cinco pabellones, a fin de prevenir que la enfermedad se propague.
Asimismo, el alcalde de la ciudad de San Bernardo informó que 50 pacientes que fueron intervenidos quirúrgicamente estuvueron expuestos al Aspergillius; además, dijo que la situación se tenía bajo control.
Por otra parte, el hongo fue detectado cuando se realizaban trabajos de remodelación que se hicieron en el área de quirófanos, lo que alarmó a las autoridades del nosocomio.
Y cómo no se detonó la alerta, pues el Hospital Público El Pino atiende a aproximadamente 403 mil pacientes de dos los municipios de San Bernardo y El Bosque.
Asimismo, la detección del hongo Aspergellius se detectó en pacientes de la Unidad de Cuidados Intensivos (UCI), obligando al cierre.
¿QUÉ ES LA ASPERGILOSOS PULMONAR?
De acuerdo con la Clínica Mayo, la aspregilosis pulmonary es una enfermedad que afecta a quienes tienen el sistema inmunológico comprometido.
Y aunque gran parte de las esporas del Aspergillius son inofensivas, pero algunas pueden dañar gravemente a los pacientes más débiles.
Entre los síntomas de la enfermedad están: fiebre y escalofríos; hemoptisis (tos que produce sangre), falta de aire, dolor en el pecho o en articulaciones; dolor de cabeza o en los ojos, así como heridas en la piel.
Por otra parte, en caso de que el paciente no reciba el tratamiento adecuado y oportunamente, puede ser mortal.
Asimismo, el hongo está presente en el suelo, en vegetales, materia orgánica en descomposición, en los alimentos y en el agua.
Los animals, como los humanos, pueden infectarse, pues las esporas del Aspergillius circulan por el aire, a través del sistema respiratorio.
También las personas inmunocomprometidas pueden infectarse si tienen heridas expuestas o por alimentos contaminados.